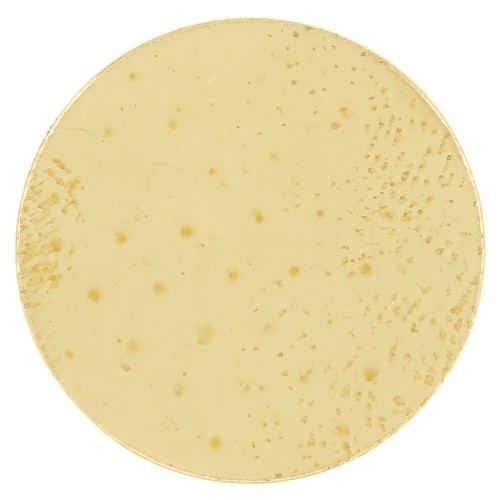
Disco 15 mm - spessore 0,8 mm - Ottone grezzo x1

Usate la vostra creatività e create tanti gioielli personalizzati con questa piastrina in ottone grezzo !
Utilizzate il Dremel per forare la piastrina rotonda su un lato per creare una medaglia, o su entrambi i lati per creare un distanziatore. È il componente ideale per una collana originale, un braccialetto fai-da-te o degli orecchini pendenti.
Date un effetto martellato con un martello per dare consistenza al metallo, oppure create un effetto striato con una fresa a sfera.
Non dimenticate di lucidarle per eliminare eventuali imperfezioni sulla vostra piastra rotonda in ottone grezzo, quindi lucidatele con una spazzola adatta per ripristinare la lucentezza.
Come utilizzare una piastra da lavoro?
Realizzate un ciondolo fai da te in modo semplice e veloce. A tale scopo, incollate strass o cabochon di pietre preziose sulla lastra grezza e foratela. Si possono creare disegni traforati sul ciondolo o creare dei timbri.
È perfetta anche per incidere o punzonare per realizzare graziosi oggetti di bigiotteria. È possibile tracciare un motivo o un'iniziale per creare gioielli personalizzati che saranno molto apprezzati.
Scoprite la nostra vasta gamma diutensili per gioielli: dremel, pinze per gioielli, punzoni ImpressArt,sega bocfil... Con un po' di pratica e destrezza, sarete in grado di realizzare tutta la vostra bigiotteria fai da te dalla A alla Z.
Specifiche:
Diametro: 15 mm
Spessore: 0,8 mm
Venduto singolarmente